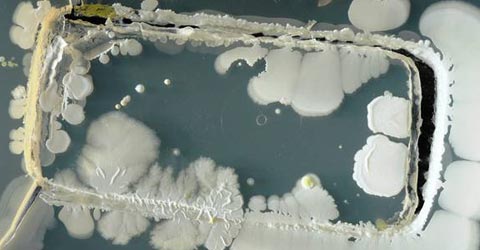

Kustantaja ja toimitus
Tietoa meistä
Oikaisukäytäntö
Ilmoita virheestä
Toimitusperiaatteet
Eettiset ohjeet
AI-käytäntö
Tietosuojalauseke
Käytämme sivustolla evästeitä parantaaksemme käyttökokemustasi. Käyttämällä sivustoa hyväksyt evästeiden tallentamisen laitteellesi.
Verkkopalvelun tiedosuojalauseke löytyy tästä.
Tiedotteet
Lehdistötiedotteet pyydetään lähettämään sähköpostitse osoitteeseen toimitus@stara.fi
Ajankohtaista

© Copyright 2003 - 2026 Stara Media Online Oy. ISSN 1795-8180 (verkkomedia). Kaikki oikeudet pidätetään.
Materiaalin luvaton julkaiseminen ja lainaaminen on kielletty.
Stara®, Viihdetaivas®, Miss Pop®, Mister Pop®, Popstar®, Tuubi® ja Jetset® ovat Stara Media Oy:n rekisteröityjä tavaramerkkejä,
joiden käyttäminen ilman lupaa on kielletty.